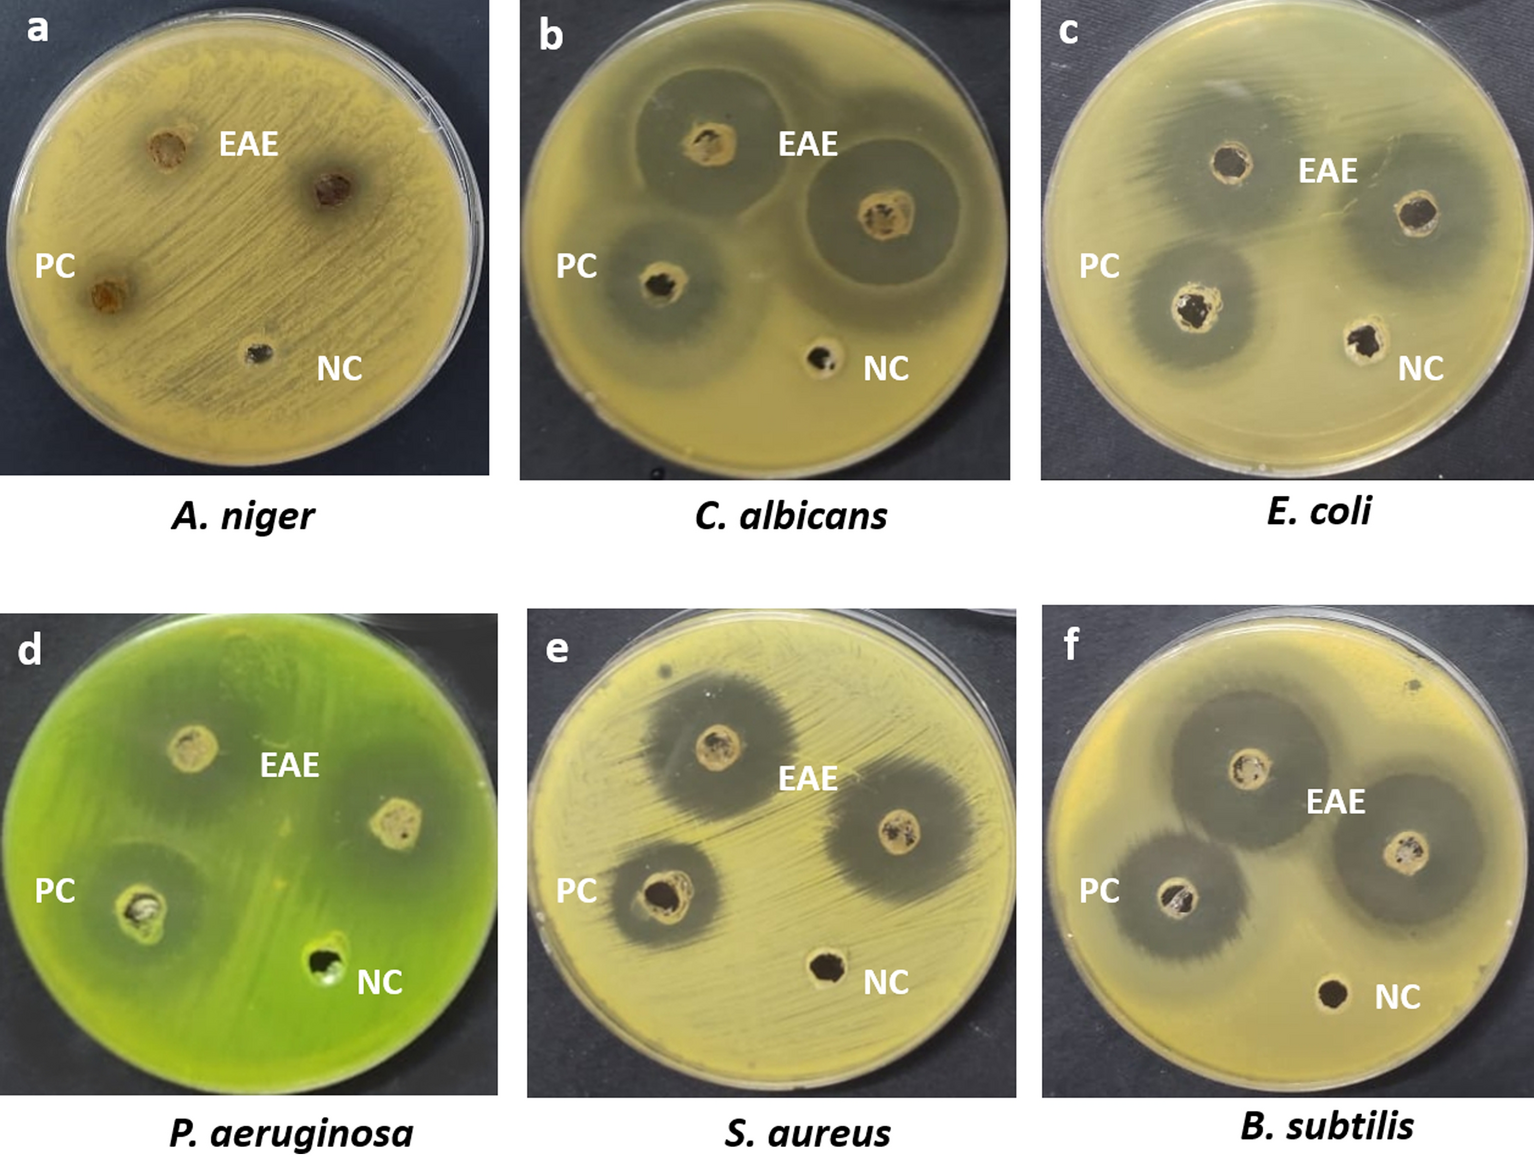
Figure 2

Figure 2
The inhibition zone (mm) of ethyl acetate crude extract (EAE) of Paecilomyces sp. (AUMC-15510) at a concentration of 5 mg/ml against (a) A. niger (b) C. albicans (c) E. coli (d) P. aeruginosa (e) S. aureus, and (f) B. subtilis. PC: Fluconazole and Gentamicin at concentration of 5 mg/ml (positive control); NC: 10% DMSO (negative control).
